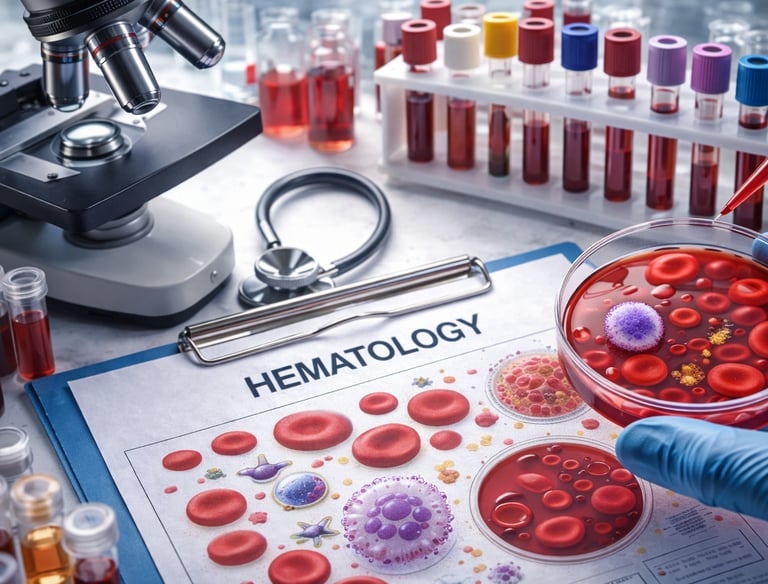
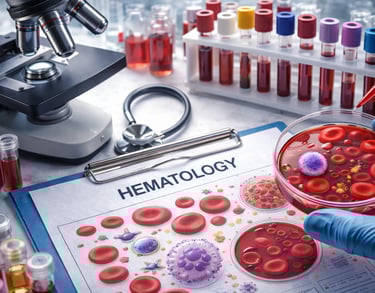

Our services
Provide a general summary of the services you provide, highlighting key features and benefits for potential clients.
CHEMISTRY


Glucose
Cholesterol
Triglycerides
HDL
BUN
BUA
Creatinine
SGOT
SGPT
HBA1C
OGTT
Sodium
Potassium
Chloride
Calcuim
Electrolytes
Lipid Profile

SEROLOGY / IMMUNOLOGY
Dengue and IGG / IGM
Dengue NS1
HIV Screening (Pre & Post Counseling)
HBSAG Screening
HCV Screening
VDRL / RPR Screening
HIV QUANTI ELISA
HBSAG QUANTI ELISA
HCV QUANTI ELISA
Pregnancy Test Serum
HAV
CBC with Platelet count
ESR
Clotting time
Bleeding time
ABO with RH Typing
Peripheral Blood Smear
Malarial Smear
Prothrombin time
APTT
HEMATOLOGY
BACTERIOLOGY


AFB SMEARS
GRAM STAIN
KOH




CLINICAL MICROSCOPY
Urinalysis
Fecalysis
Fecal Occult Blood
Pregnancy Test Urine
ECG
CHEST X-RAY
TB QUANTIFERON
PAPSMEAR SLIDE
PAPSMEAR READING
MEDICAL CONSULTATION


